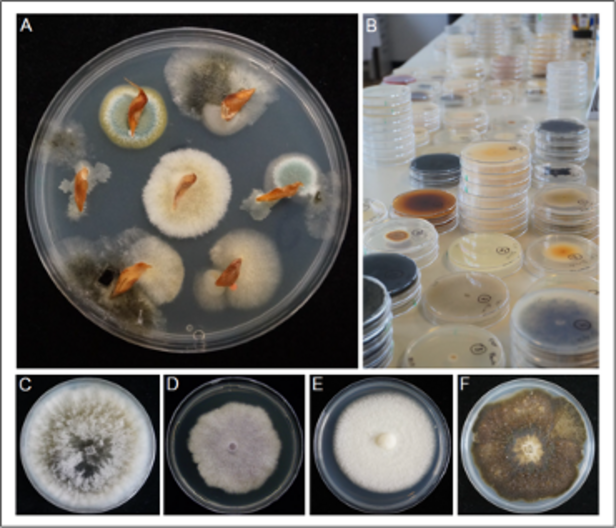
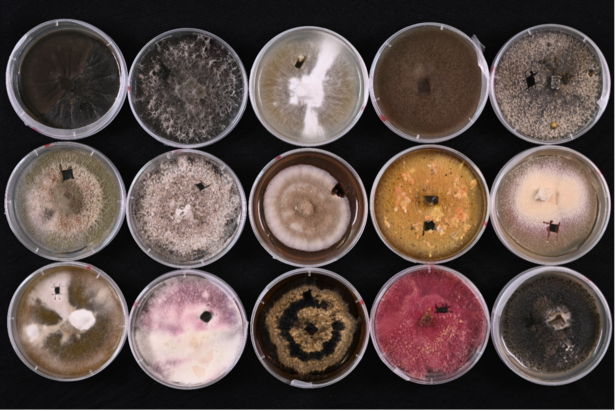

Biodiversity Seminar: Revealing the Hidden Diversity of Tree Seed Mycobiota and Their Impact on Tree Health
Datum:
Ort:
WSL Birmensdorf, Hörsaal
Organisiert von:
Nadia Castro Izaguirre, WSL
Vortrag:
Iva Franić, WSL
Moderation:
Simone Prospero, WSL
Sprache(n):
English
Veranstaltungstyp:
Vorträge und Kolloquien
Zielpublikum:
Anyone interested in the topics
Abstract ¶
Besides providing nutrients and protection for plant embryo development, seeds nurture complex communities of microorganisms such as fungi and bacteria. These communities consist of potentially beneficial microorganisms that enhance seedling vigor and resilience, and organisms with pathogenic potential that threaten plant vitality. Most of these microorganisms exist in seeds in their dormant or latent forms, expressing their functions during germination and seedling development with profound impacts on plant development and health. While the importance of understanding seed microbiota for fostering healthy plant growth is undeniable, their exploration within forest tree seeds has long been underexplored. Our recent studies, in which we employ traditional culturing and DNA- and RNA-based amplicon sequencing to study tree seed fungi, show that tree seeds harbor highly diverse fungal communities primarily shaped by host species, likely due to the prevalence of vertical transmission. Our results demonstrate that tree seeds, like more studied seeds or agricultural plants, serve as reservoirs of fungal inoculum for seedlings. Roughly one-third of these fungi have pathogenic potential, calling for cautious seed exchange to safeguard forest ecosystems. However, for a large fraction of seed fungi, their function and interactions within seed microbiota remain unknown. Further research is thus necessary to unlock the full potential of tree seed microbiota in shaping trees and forest ecosystems.

About the speaker ¶
Iva Franić obtained her Ph.D. from the University of Bern in 2020, after which she spent two and a half years as an SNSF postdoc fellow at the Swedish University of Agricultural Sciences. Since September 2023, she has worked as a scientist in the Phytopathology group, Forest Health and Biotic Interactions Unit at WSL. Her research interests focus on exploring the diversity patterns, assemblage processes, and functions of tree microbiota with an overall aim to reduce the risk of introducing novel pathogens via plant trade and to identify potentially beneficial microorganisms that could be used to increase trees' resistance to biotic and abiotic stresses.
Biodiversity Seminars ¶
The Biodiversity Seminar Series is organized by the WSL Biodiversity Center. Every two weeks, we aim to host a seminar speaker who presents research or outreach on topics relevant to the biodiversity community at WSL. The seminars are public and are broadcast online. If you would like to access the live stream, please email events-biodiversity(at)wsl.ch.
Please visit our website to learn more about the WSL Biodiversity Center and view a complete list of events.
Contact ¶
How to get here ¶
Zürcherstrasse 111, 8903 Birmensdorf
By public transport ¶
Bus stop Birmensdorf ZH, Sternen/WSL
Accessible by bus lines 220 and 350 via Wiedikon/Triemli or via Birmensdorf station with S-Bahn lines 5 and 14.
By car ¶
See map on map.search.ch or Google Maps
You'll find guest parking spaces (for a fee) behind the main building after passing the main entrance.
